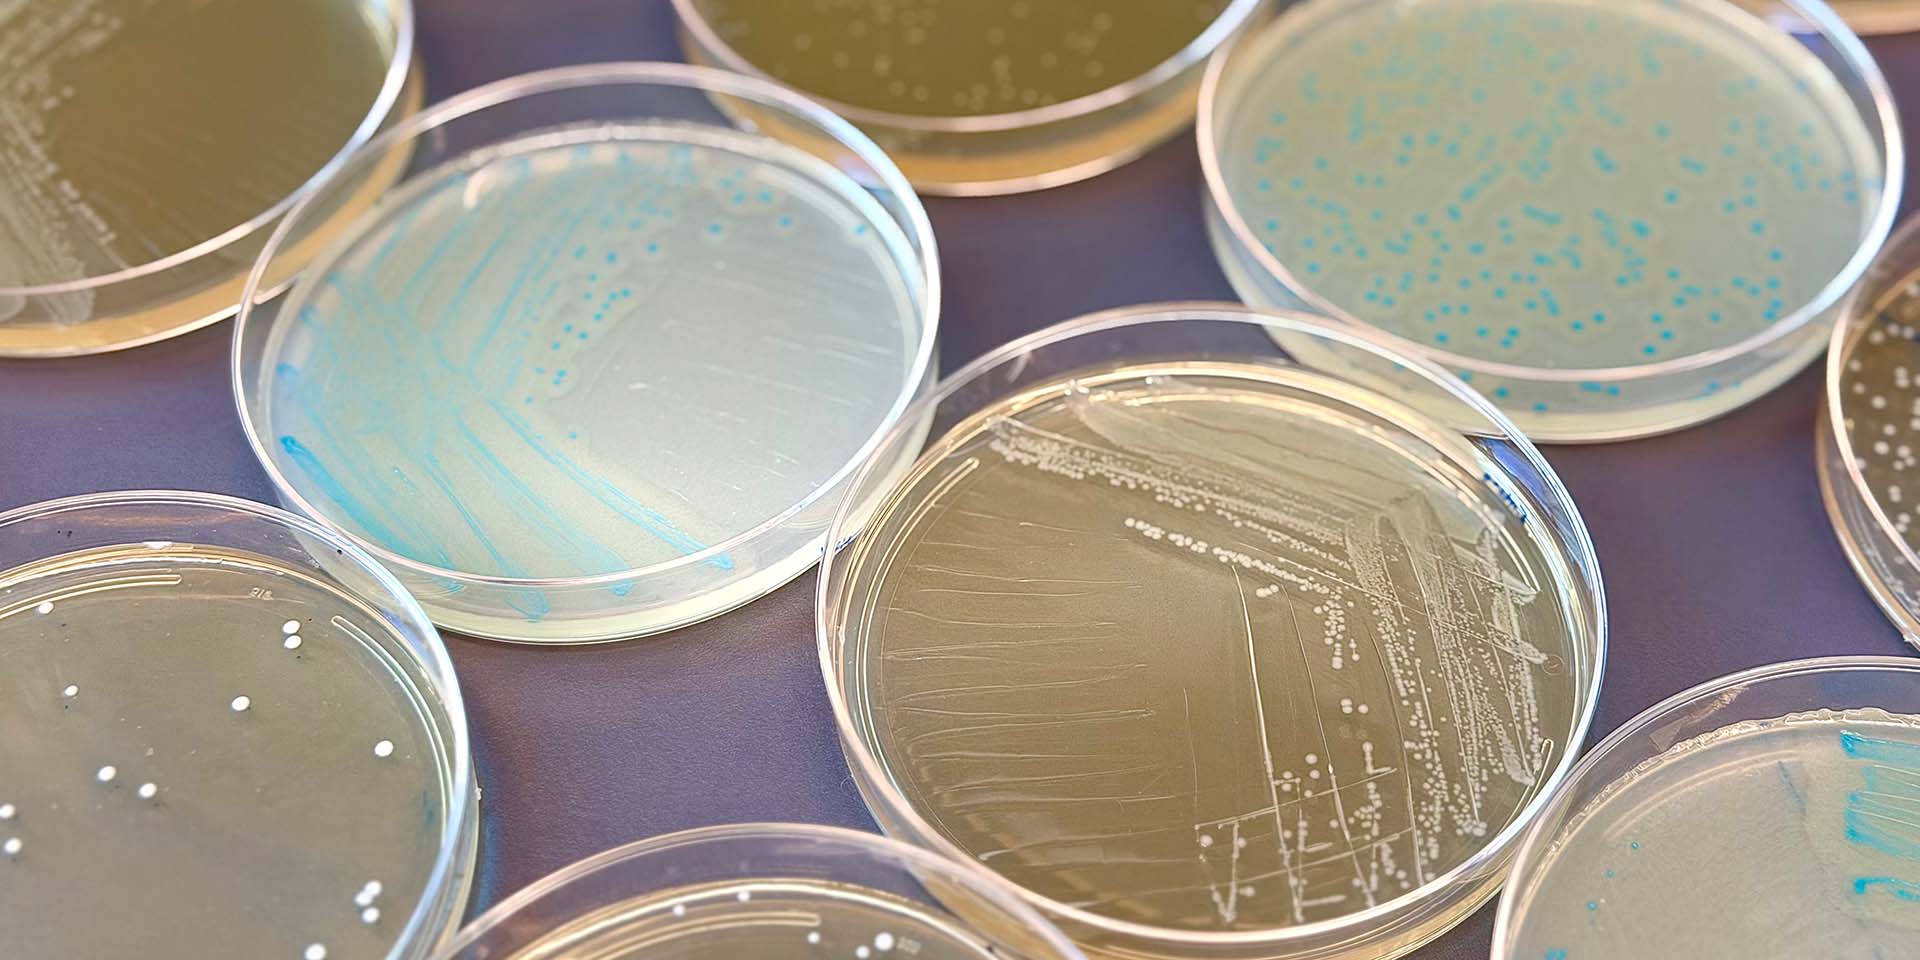
Petri dishes used in research

Armistead Lab
Investigating T Cells in Human Milk as a Tool to Prevent Infectious Diseases in Early Life
Worldwide, respiratory and enteric infections are leading causes of death and illness in children under one year of age. Exposure to breastmilk in the first year of life is protective against both the incidence and severity of these infections, an effect most often attributed to the passive transfer of bioactive compounds in human milk such as antibodies. However, human milk also contains a high frequency of T cells, which have unknown specificity and function.
Mechanistic studies on the establishment, specificity, response and protective function of breastmilk T cells are needed to more completely understand how breastmilk bolsters protective immunity against respiratory and enteric pathogens during the critical window of vulnerability in infancy. Further, such studies are essential to the rational design of maternally directed strategies that aim to maximize the immunologic benefits conferred to nursing infants and subsequently reduce the burden of infection in infancy.
The Armistead Lab at Seattle Children’s investigates cellular immunity in the lactating breast as a novel therapeutic target for the prevention and treatment of respiratory and enteric infections in infants. We seek to accomplish this through three overarching projects that aim to:
- Elucidate a novel respiratory-mammary axis of T cell immunity.
- Define the pathogen-specific T cell repertoire in human breastmilk.
- Investigate mechanisms of milk-derived T cell immunity in offspring using preclinical models.

Blair Armistead, PhD, MPH
Dr. Armistead received her MPH from Virginia Commonwealth University, during which she conducted community health outreach related to sexual and reproductive health. She received her PhD in Pathobiology from the University of Washington, where she completed her dissertation research in the lab of Dr. Lakshmi Rajagopal focused on pathogens that affect pregnancy, including Group B Streptococcus. She conducted her postdoctoral training in the lab of Dr. Whitney Harrington, where she studied the maternal and infant immune systems. Outside of work, she enjoys spending time with her family, going on runs, seeing live shows and watching women's sports.
-

Holly Barrett, PhD
Postdoctoral Researcher
Holly earned her PhD in Pathobiology at UW, studying vaccine-mediated T cell responses against M. tuberculosis. Her current interests include using translational approaches to study breastmilk T cells in the context of infectious diseases. Outside the lab, she and her partner enjoy board games and training their dog.
-

Caitlin Ginn
Undergraduate Student
Caitlin is an undergraduate at the University of Washington, studying Biology and Art. In the Armistead Lab, she works on the growth and curation of the lab’s clinical sample repository. In her free time, she likes to sail, do ceramics and cook.
-

Phoenicia Quach
Research Associate III
Phoenicia earned her B.S. in Biology from the University of Washington while working in the Rajagopal Lab at Seattle Children’s Research Institute. She then transitioned into the biotech industry for several years focusing on IND- enabling and preclinical in vitro/ in vivo studies in both cancer and autoimmune therapies. Outside of the lab, she enjoys cooking for friends and family and camping.
